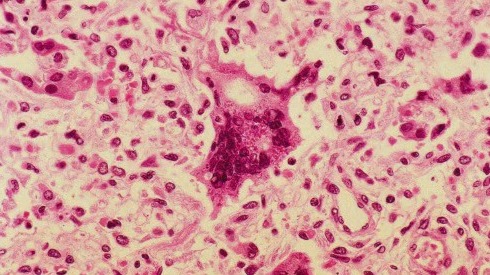
Measles detected in Austin wastewater

Food options at Fareground in downtown Austin
There are a lot of spots and different cuisines to check out at Fareground. Tierra highlights Golden Boy, Austin Rotisserie and Four Brothers.
There are a lot of spots and different cuisines to check out at Fareground. Tierra highlights Golden Boy, Austin Rotisserie and Four Brothers.
Car insurance 101: Pay less and stay covered
Getting insurance for your car can be expensive but there are ways you can save. Finance professor Dan Roccato has some tips and advice.
Getting insurance for your car can be expensive but there are ways you can save. Finance professor Dan Roccato has some tips and advice.
Hot Wheels Legends Tour in Central Texas
Hot Wheels lead designer Rob Matthes talks about what to expect from the event that's going on July 26 in Cedar Park.
Hot Wheels lead designer Rob Matthes talks about what to expect from the event that's going on July 26 in Cedar Park.
FAIDA Foods bringing African flavor to TX kitchens
Founder Christian Lola talks about the the locally made hot sauce inspired by African roots and purpose-driven passion and shares the story behind it.
Founder Christian Lola talks about the the locally made hot sauce inspired by African roots and purpose-driven passion and shares the story behind it.
Aubrey Logan performs in FOX 7 Austin studios
Trombone playing singer-songwriter Aubrey Logan talks about her show on July 25 at LIVE at ACL Live with Jo James and performs a song.
Trombone playing singer-songwriter Aubrey Logan talks about her show on July 25 at LIVE at ACL Live with Jo James and performs a song.
Fleur at Austin Animal Center
We get more information about a dog looking for a good home and about an upcoming event at the Austin Animal Center.
We get more information about a dog looking for a good home and about an upcoming event at the Austin Animal Center.
Fleming Studios & LM Adornment at Vibe Markets
Vibe Artisan Markets is hosting its Austin summer event his weekend at Distribution Hall. The community can shop more than 100 artisans while enjoying entertainment, drinks and more. Tierra gets details and gets a look at a couple of the artisans.
Vibe Artisan Markets is hosting its Austin summer event his weekend at Distribution Hall. The community can shop more than 100 artisans while enjoying entertainment, drinks and more. Tierra gets details and gets a look at a couple of the artisans.
Tak Tak Goods, The Gardener's Wife at Vibe Markets
Vibe Artisan Markets is hosting its Austin summer event his weekend at Distribution Hall. The community can shop more than 100 artisans while enjoying entertainment, drinks and more. Tierra gets details and gets a look at a couple of the artisans.
Vibe Artisan Markets is hosting its Austin summer event his weekend at Distribution Hall. The community can shop more than 100 artisans while enjoying entertainment, drinks and more. Tierra gets details and gets a look at a couple of the artisans.
Martfoot Made, Desert Willow Glass at Vibe Markets
Vibe Artisan Markets is hosting its Austin summer event his weekend at Distribution Hall. The community can shop more than 100 artisans while enjoying entertainment, drinks and more. Tierra gets details and gets a look at a couple of the artisans.
Vibe Artisan Markets is hosting its Austin summer event his weekend at Distribution Hall. The community can shop more than 100 artisans while enjoying entertainment, drinks and more. Tierra gets details and gets a look at a couple of the artisans.
Zach Carney performs in FOX 7 Austin studios
Musician Zach Carney talks about upcoming shows at Bucks Backyard on 7/24 and every Sunday at Rustic Tap and then he performs a song.
Musician Zach Carney talks about upcoming shows at Bucks Backyard on 7/24 and every Sunday at Rustic Tap and then he performs a song.
Special Olympics Unified Sports MLS All-Star Game
There is so much going on leading up to Major League Soccer's All-Star Game at Q2 Stadium tonight. Jessica Rivera has the details.
There is so much going on leading up to Major League Soccer's All-Star Game at Q2 Stadium tonight. Jessica Rivera has the details.
Summer fun in Houston: Austin Travels
Looking for a quick summer getaway? Lots of fun things to do just a few hours away from Austin. Kristin Finan has the details.
Looking for a quick summer getaway? Lots of fun things to do just a few hours away from Austin. Kristin Finan has the details.
Sun Radio's Sun Radiothon helping flood victims
This year's third annual Sun Radiothon has even more purpose as Sun Radio is partnering with Kerrville Pets Alive and NAMI Central Texas for four straight days of music and mission. Nakia has all the details.
This year's third annual Sun Radiothon has even more purpose as Sun Radio is partnering with Kerrville Pets Alive and NAMI Central Texas for four straight days of music and mission. Nakia has all the details.
Dave Scher performs in FOX 7 Austin studios
Musician Dave Scher talks about his upcoming show The 04 Center on August 2 and performs one of his songs.
Musician Dave Scher talks about his upcoming show The 04 Center on August 2 and performs one of his songs.
Measles detected in Austin wastewater
Health officials are reminding people to get vaccinated after detecting measles in Austin's wastewater. Dr. Pradeep Kumar from Austin Gastroenterology has the details.
Health officials are reminding people to get vaccinated after detecting measles in Austin's wastewater. Dr. Pradeep Kumar from Austin Gastroenterology has the details.
Learning to triage your stress
Stress can be both beneficial and harmful but how do you lean into the good and shake off the bad? FOX Medical Team's Deena Centofanti shares some insight.
Stress can be both beneficial and harmful but how do you lean into the good and shake off the bad? FOX Medical Team's Deena Centofanti shares some insight.
NASA launching NISAR in partnership with India
A groundbreaking satellite developed in partnership with India is set to launch. NISAR is expected to deliver ultra-precise Earth data and marks the first U.S-India join space mission and major leap in satellite technology. NASA Director of Earth Science Dr. Karen St. Germain has all the details.
A groundbreaking satellite developed in partnership with India is set to launch. NISAR is expected to deliver ultra-precise Earth data and marks the first U.S-India join space mission and major leap in satellite technology. NASA Director of Earth Science Dr. Karen St. Germain has all the details.
Showcase puts spotlight on future of soccer
With the MLS All-Star Game in town, tech is meeting talent in a whole new way. Chris Schlosser has more on the The Future of the Game Showcase.
With the MLS All-Star Game in town, tech is meeting talent in a whole new way. Chris Schlosser has more on the The Future of the Game Showcase.
MLS All-Star Game: Future of the Game Showcase
Soccerment's Aldo Comi and Wicket's Glenn Bormann talk about an event going on that looks at soccer tech.
Soccerment's Aldo Comi and Wicket's Glenn Bormann talk about an event going on that looks at soccer tech.
MLS All-Star Game: Skills challenge
FOX 7 Austin's Meredith Aldis heads out to Q2 Stadium to test out her skills on the pitch.
FOX 7 Austin's Meredith Aldis heads out to Q2 Stadium to test out her skills on the pitch.